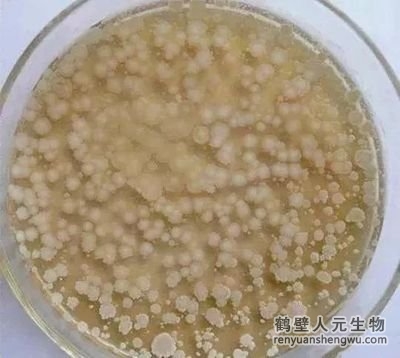

【內(nèi)容摘要】
纖維素酶、半纖維素酶:植物殘?bào)w(如秸稈、落葉)中占比最高的是纖維素(約 30%-50%)??莶菅挎邨U菌可分泌纖維素酶,將纖維素分解為纖維二糖,最終轉(zhuǎn)化為葡萄糖;同時(shí)分泌半纖維素酶,分解半纖維素為木糖等單糖。
蛋白酶、淀粉酶、脂肪酶:針對(duì)土壤中動(dòng)物殘?bào)w、植物分泌物或微生物殘?bào)w中的 “易分解有機(jī)質(zhì)”:蛋白酶可將蛋白質(zhì)分解為多肽和氨基酸;淀粉酶可將淀粉(如植物種子殘?bào)w中的淀粉)分解為麥芽糖和葡萄糖;脂肪酶則能分解脂肪為甘油和脂肪酸。
其他輔助酶類:如磷酸酶(分解有機(jī)質(zhì)中的有機(jī)磷,釋放無機(jī)磷)、脲酶(輔助分解含氮有機(jī)質(zhì))等,雖不直接針對(duì)有機(jī)質(zhì)的 “骨架”,但能促進(jìn)有機(jī)質(zhì)中養(yǎng)分的釋放,間接加速整體分解過程。
這些酶類的分泌具有 “適應(yīng)性”—— 當(dāng)土壤中某類有機(jī)質(zhì)(如秸稈)含量較高時(shí),枯草芽孢桿菌會(huì)通過基因調(diào)控優(yōu)先合成對(duì)應(yīng)酶(如纖維素酶),提高分解效率。

枯草芽孢桿菌分解有機(jī)質(zhì)的過程,本質(zhì)是其 “獲取能量、維持生長(zhǎng)” 的代謝過程:
當(dāng)酶將復(fù)雜有機(jī)質(zhì)分解為小分子(如葡萄糖、氨基酸)后,枯草芽孢桿菌會(huì)通過 “呼吸作用”(有氧呼吸為主,因枯草芽孢桿菌是好氧菌)將這些小分子氧化分解,釋放能量(供自身繁殖),同時(shí)產(chǎn)生代謝產(chǎn)物(如二氧化碳、水、有機(jī)酸、氨等)。 這個(gè)過程中,一方面,有機(jī)質(zhì)被 “徹底分解”(最終部分轉(zhuǎn)化為二氧化碳和水,部分轉(zhuǎn)化為微生物自身的生物量,即 “微生物體”);
另一方面,產(chǎn)生的小分子物質(zhì)(如氨基酸、有機(jī)酸)和代謝產(chǎn)物會(huì)成為土壤中其他微生物(如真菌、放線菌)的 “營(yíng)養(yǎng)源”,間接促進(jìn)整個(gè)微生物群落的活性,形成 “群落協(xié)同分解” 的效應(yīng) —— 例如,枯草芽孢桿菌分解纖維素產(chǎn)生的葡萄糖,可被真菌利用,而真菌能分解枯草芽孢桿菌難以直接分解的木質(zhì)素,二者互補(bǔ),加速整體有機(jī)質(zhì)的分解。

除直接的 “酶解 + 代謝” 作用外,枯草芽孢桿菌還能通過改變土壤物理、化學(xué)條件,間接促進(jìn)有機(jī)質(zhì)分解:
改善土壤通氣性:枯草芽孢桿菌是好氧菌,其生長(zhǎng)繁殖需要氧氣,而它的活動(dòng)(如在土壤顆粒間定植、代謝產(chǎn)生氣體)可疏松土壤(尤其針對(duì)黏重土壤),增加土壤孔隙度,提高氧氣含量;同時(shí),氧氣充足也能促進(jìn)其他好氧微生物(如分解有機(jī)質(zhì)的主要菌群)的活性,而好氧條件下有機(jī)質(zhì)分解更徹底(厭氧分解易產(chǎn)生甲烷等不完全產(chǎn)物,效率低)。
調(diào)節(jié)局部 pH 和養(yǎng)分微環(huán)境:枯草芽孢桿菌代謝會(huì)產(chǎn)生有機(jī)酸、氨等物質(zhì),可局部調(diào)節(jié)土壤微環(huán)境的 pH(避免過酸或過堿抑制酶活性);同時(shí),其分解有機(jī)質(zhì)釋放的氮、磷等養(yǎng)分,可提高土壤 “速效養(yǎng)分” 含量,為自身及其他分解菌提供營(yíng)養(yǎng),形成 “分解 - 釋養(yǎng) - 促生長(zhǎng)” 的循環(huán)。
如果您對(duì)“枯草芽孢桿菌如何促進(jìn)土壤有機(jī)質(zhì)的分解”還有任何疑問?
歡迎撥打人元有機(jī)肥設(shè)備廠家電話:15303928500,或點(diǎn)擊訂購文章中介紹到的設(shè)備。

電話:
15303928500

郵箱:
renyuanshengwu@163.com

地址:
河南省鶴壁市淇濱區(qū)東楊莊工業(yè)園區(qū)德方路富春江路1路
Copyright ? 2006-2025 鶴壁市人元生物技術(shù)發(fā)展有限公司 版權(quán)所有 丨 備案號(hào):豫ICP備06002949號(hào)-1 丨 豫公網(wǎng)安備:41060202000002 丨 360安檢 丨 網(wǎng)站地圖 丨 XML